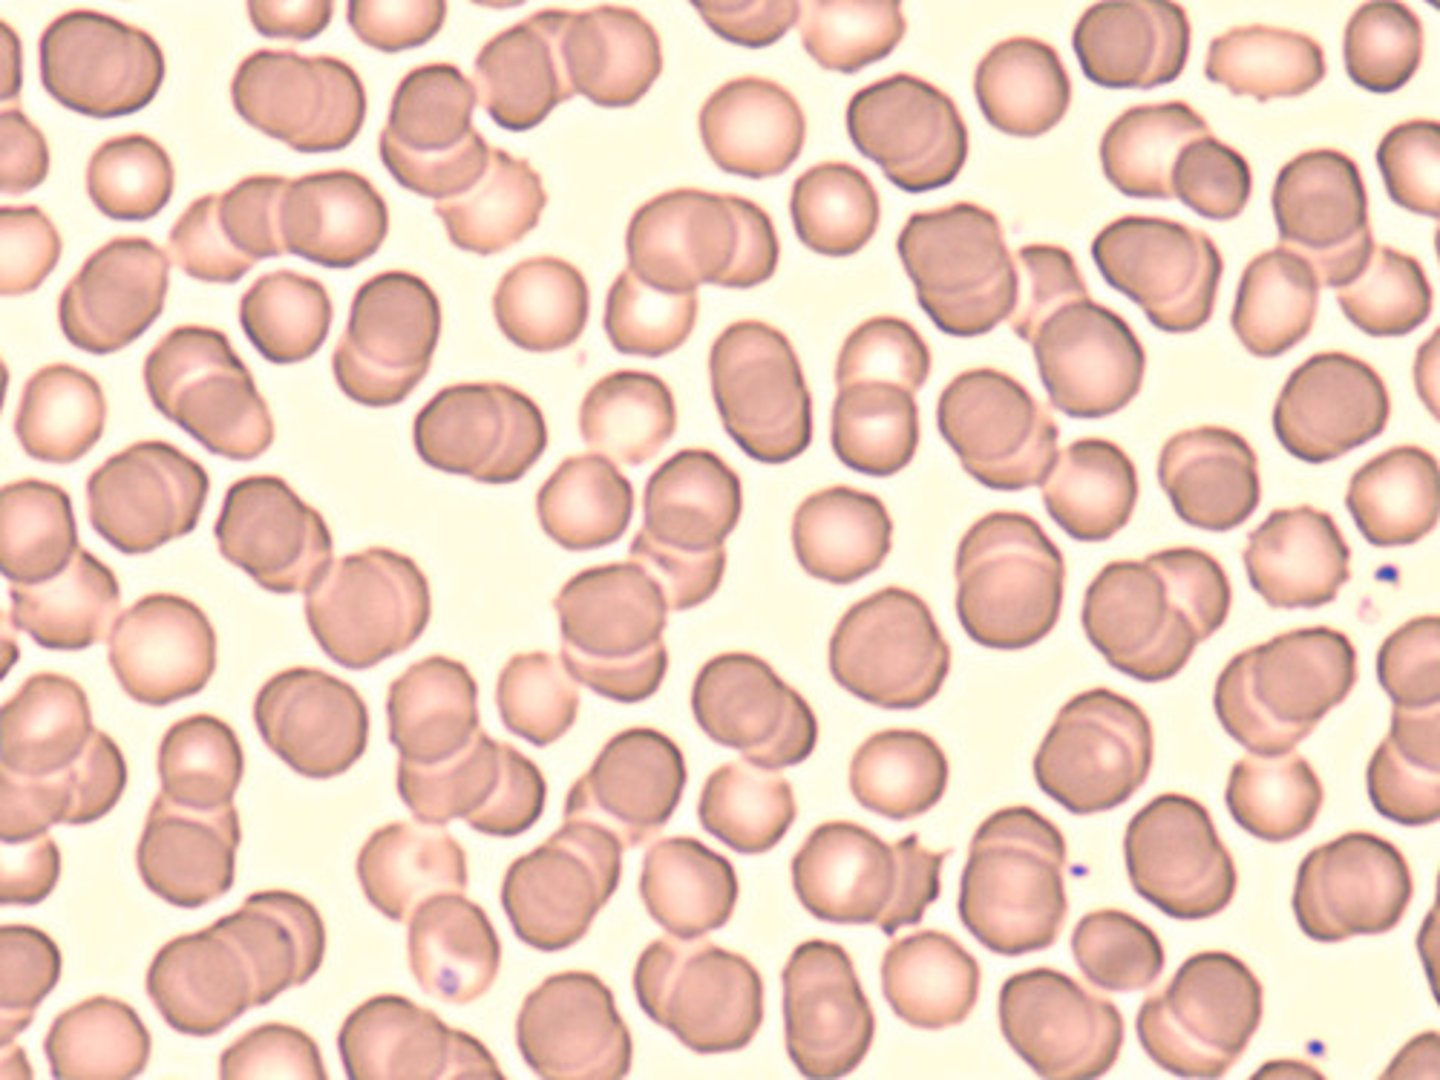
<p>most numerous blood cells that are reddish pink colored and lack a nucleus &amp; most organelles</p>
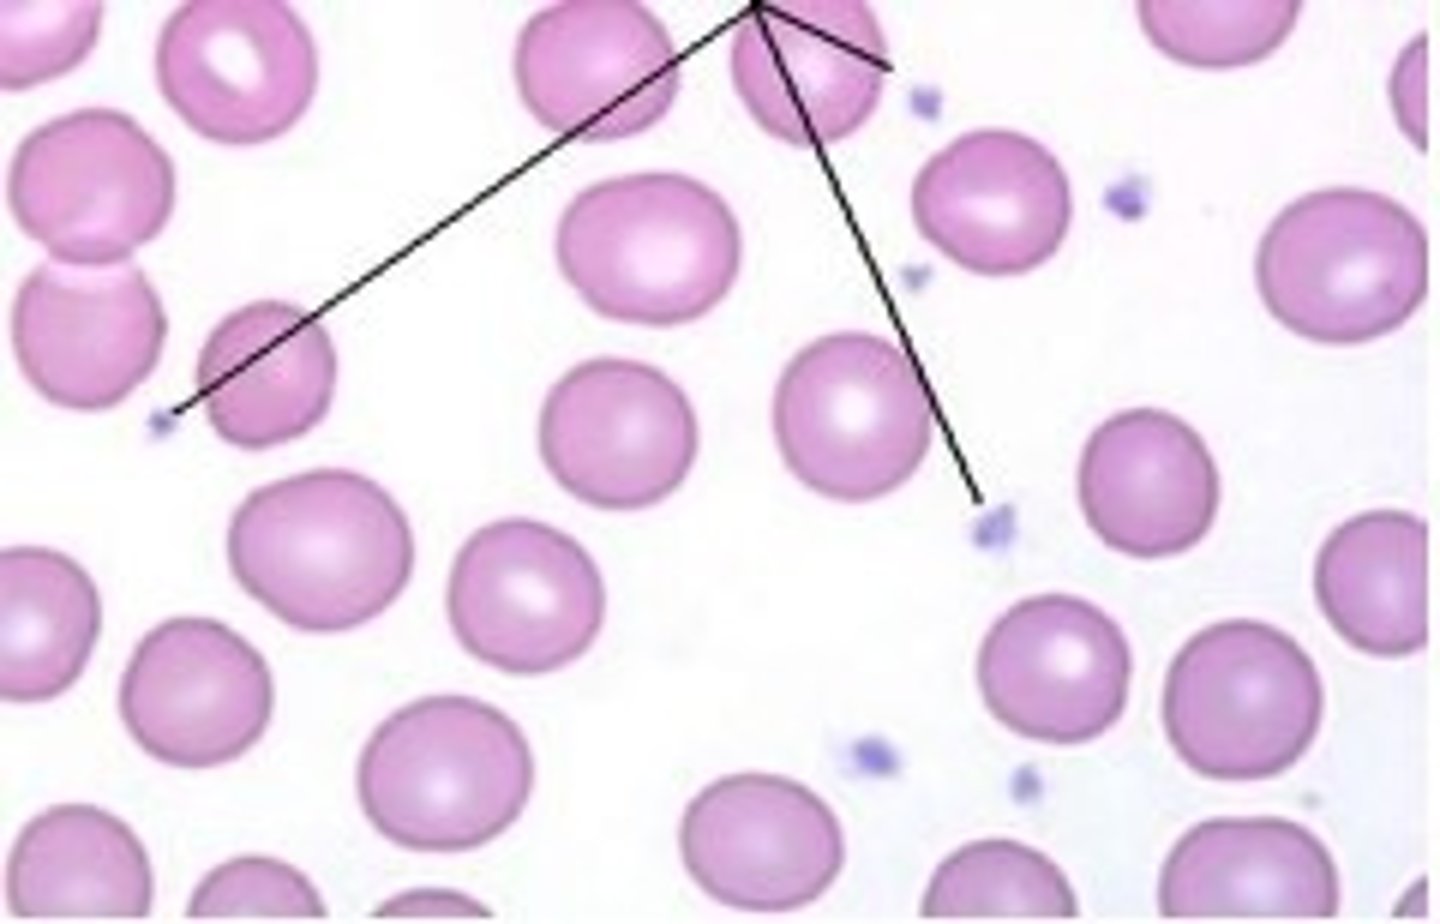
<p>cellular fragments involved in clotting that lack nuclei &amp; most organelles &amp; are very small</p>

1/111
Looks like no tags are added yet.
Name | Mastery | Learn | Test | Matching | Spaced | Call with Kai |
|---|
No analytics yet
Send a link to your students to track their progress
what are the 3 major circuits of blood flow in the body?
systemic, coronary, pulmonary
what is the flow of blood in the systemic circuit?
Left Ventricle → Systemic Arteries → Arterioles → Capillary Beds (body tissues) → Venules → Systemic Veins → Right Atrium
what is the flow of blood through the coronary circuit?
Left Ventricle → Aorta → Coronary Arteries → Arterioles → Capillary Beds (Heart Muscle / Myocardium) → Venules → Cardiac Veins → Coronary Sinus → Right Atrium
how is the coronary circuit different from the systemic circuit?
the coronary circuit's arteries, capillary beds, & veins only supply & drain the heart (instead of the entire body)
What is the flow of blood in the pulmonary circuit?
Right Ventricle → Pulmonary Arteries → Capillaries (Lungs) → Pulmonary Veins → Left Atrium
what is apical pulse?
actual contraction of the heart that's felt on the apex of the heart
what is peripheral pulse?
pressure wave generated by the left ventricle ejecting blood into the arteries
what is pulse deficit?
difference between apical pulse rate & peripheral pulse rate
when does pulse deficit occur?
when not every heart beat produces a palpable pulse wave that can be felt at a peripheral artery
what are the 2 cardiac muscle cells found in the heart?
pacemaker & contractile cells
(less pacemakers)
what are pacemaker cells?
unique cells that rhythmically & spontaneously depolarize & have action potentials
what are contractile cells?
cells whose depolarization & AP is triggered by pacemaker cells' depols
what are the 3 groups of pacemaker cells?
SA node, AV node, purkinje fibers
what is the SA node?
node in the superior portion of the right atrium that depols about 60 times per minute & is the normal pacemaker of the heart
what is the AV node?
- node located in the posterior right atrium & is medial to the tricuspid valve
- depols 40 times per minute & acts as backup pacemaker if the SA stops working
what is the purkinje fiber system?
1. when the AV node travels to the inferior interatrial septum & superior interventricular septum
2. AV bundle splits into right & left bundle branches that run down the right & left sides of the interventricular septum
3. near the heart apex, the bundles split into terminal branches that fan out through the ventricles & contact ventricular contractile cells
what is the cardiac conduction system?
when the 3 groups of pacemaker cells work together to allow depols from pacemakers cells to spread extremely rapidly to other pacemaker & contractile cells
what is the flow path of the spread of APs?
SA node
↓
Atrial conducting fibers
↓
Atrial contractile cells (atria depolarize and contract)
↓
AV Node (AV nodal delay)
↓
AV bundle (Bundle of His)
↓
Right and Left bundle branches (along interventricular septum)
↓
Purkinje fibers (terminal branches)
↓
Ventricular contractile cells (ventricles depolarize and contract)
what does the AV node connect?
atria & ventricles
what happens if the AV node is blocked?
atria may be paced by SA node & ventricles by AV node or purkinje fiber system, which leads to diff heart rates & rhythms
what is an ECG?
way to measure electrical activity of the heat via recording the changes that occur in the electrical activity of the cardiac muscle cells over a period of time
electrical activity does not guarantee...
mechanical contraction (ex: electrical system can be working while the mechanical pump is failing)
how do you measure electrical activity of the heart?
by placing electrodes on the surface of the skin to detect changes in the heart's electrical signals
what do electrical signals show up as on ECGs?
waves
what happens when there is no net change in electrical activity?
ECG is flat
what does a flat line between waves indicate?
means heart cells are still in diff phases of their APS
why does the ECG appear flat during pacemaker cells APs?
because there are very few pacemaker cells in the heart, & their electrical activity is too small to be detected by a standard ECG
list the components of one ECG wave
•SA node fires (electrical, not seen on ECG)
•P wave appears (atria depolarize)
•Atria contract (push blood into ventricles)
•QRS complex appears (ventricles depolarize)
•Ventricles contract (ventricular systole)
•T wave appears (ventricles repolarize)
•Ventricles relax (diastole)
what is the P wave?
- depol of left & right atria
- small bc atria contain fewer cells than ventricles
what is the flat segment just before the P wave?
depol of SA node (not visible on ECG)
what is the QRS complex?
- set of 3 waves that represents depol of left & right ventricles
- large size of it results from large number of ventricular cells
what is the T wave?
- repol of ventricles
- sometimes a small U wave will follow (represents repol of terminal branches)
what are the 2 types of measurements on an ECG?
intervals (includes waves)
segments (waves not included)
what is the P-P & R-R interval?
- time between 2 P or R waves
- represents the duration of the generation & spread of an AP through the heart
- can determine heart rate
what should happen with the P-P and R-R intervals under normal conditions?
they should match since every depol from the SA node should leave to depol of both ventricles and both atria
what is the P-R interval?
- beginning of P wave to beginning of QRS complex
- interval that represents conduction from the SA node to the atria to the AV node to the ventricles (includes AV node delay)
what is the Q-T interval?
- beginning of Q wave to end of T wave
- interval that represents ventricular depol & repol
What is the S-T segment?
- end of S wave to beginning of T wave
- occurs during ventricular plateau phase
- normally flat due to no net change in electrical activity
what is normal sinus rhythm?
where the SA node is the pacemaker and has the heart rate at 60-100 bpm (aka normal conduction from atria to ventricles)
what is dysrhythmia?
aka arrhythmia; any deviation from normal sinus rhythm
what is the dicrotic notch?
the moment of aortic valve closure that's caused by a brief backflow of blood against the aortic valve, followed by the elastic recoil of the arterial wall, which produces a small dip in the pulse pressure wave
what are heart sounds produced by?
the closing of valves during the cardiac cycle
what is S1?
the first heart sound caused by simultaneous closure of the mitral & tricuspid valves
- occurs when ventricles contract
- happens during isovolumetric contraction
what is S2?
the second heart sound caused by the simultaneous closure of the aortic & pulmonary valves
- occurs when ventricles relax
- happens during isovolumetric relaxation
what is S3?
an additional heart sound that occurs after S2
what is S4?
an additional heart sound that occurs prior to S1
what is a heart murmur?
a clicking or swooshing noise between heart sounds that can be caused by regurgitation (valve leak) or stenosis (valve narrow)
what is auscultation?
the process of listening to heart sounds
how many spaces is the heart auscultated in?
4 (each area is named for the valve best heard at that location)
what are the 4 auscultation areas?
aortic area
pulmonic area
tricuspid area
mitral area
where is the aortic auscultation area?
at the second intercostal space (between ribs 2 & 3) on the right sternal border

where is the pulmonic auscultation area?
at the second intercostal space (between ribs 2 & 3) on the left sternal border

where is the tricuspid auscultation area?
in the fourth intercostal space (between ribs 4 & 5) on the left sternal border

where is the mitral auscultation area?
in the fifth intercostal space (between ribs 5 & 6) on the left midclavicular line

what heart rates indicate tachycardia?
over 100 bpm
what heart rates indicate bradycardia?
less than 60 bpm
what is heart rhythm?
pattern & regularity of heartbeats
what does it mean if a heart rhythm is regularly irregular?
the rhythm is irregular but still follows a defined pattern
what does it mean if a heart rhythm is irregularly irregular?
the rhythm follows no set pattern
what is the bell of a stethoscope used for?
to heart low pitched sounds
what is the diaphragm of the stethoscope do?
used to hear lighter heart sounds
A patient's apical pulse is recorded as 90 beats/min, while their radial pulse is 78 beats/min. What explains this difference?
Some ventricular contractions do not generate enough pressure to produce a palpable peripheral pulse.
what is pulse point?
location point on the body where an artery can be palpated with fingertips to determine the rate, rhythm, & regularity of a heartbeat
What happens to the T wave during intense exercise?
its amplitude increases, reflecting faster ventricular repol
After moderate aerobic exercise, what type of autonomic adjustment most directly contributes to ECG changes such as a shorter R-R and P-R interval?
Increased sympathetic stimulation and decreased parasympathetic activity
what is blood pressure?
pressure exerted by the blood on the walls of the blood vessels
what are the 3 factors that determine blood pressure?
cardiac output, peripheral resistance, & blood volume
what is cardiac output?
amount of blood each ventricle pumps in 1 minute
- product of heart rate & stroke volume (aka amount of blood pumped with each beat)
what is resistance?
any impedance to blood flow encountered in the blood vessels
how is resistance determined?
by degree of vasoconstriction (incr resistance) or vasodilation (decr resistance) in the systemic circulation
what other factors influence resistance?
obstructions such as atheromatous plaques in arteries
what is peripheral resistance?
blood resistance that's highest in blood vessels located away from the heart
what is blood volume?
amount of blood found in blood vessels at any given time
what is blood volume influenced by?
overall fluid volume & controlled by kidneys & hormones of the endocrine system
son, im endoCRINE

what two factors can be altered to quickly change blood pressure?
cardiac output & peripheral resistance
(blood volume alterations take much longer)
what is aterial blood pressure?
systolic & diastolic blood pressure measured clinically & experimentally using a sphygmomanometer & stethoscope
what is systolic pressure?
pressure in the arteries during period of ventricular contraction, called ventricular systole (larger number that averages between 100 & 120 mmHg)
what is diastolic pressure?
pressure in arteries during ventricular relaxation or ventricular diastole (smaller number, averages between 60 & 80 mmHg)
what happens when the sphygmomanometer cuff is inflated?
it compresses the brachial artery & cuts off blood flow
what happens when the pressure from the sphygmomanometer cuff is released to the level of systolic arterial pressure?
blood flow through the brachial artery resumes, but is also turbulent, causing the 1st korotkoff sound
what is the last korotkoff sound?
the last sound heard before the blood stops being turbulent (represents diastolic pressure)
During moderate exercise, what changes in blood pressure are most likely to occur?
- Systolic pressure increases due to greater cardiac output
- diastolic pressure remains the same or decreases slightly due to vasodilation in active muscles
what is blood?
type of connective tissue that is distributed through the body by the cardiovascular system
what are the functions of blood?
•exchanging gases
•distributing solutes
•performing functions of the immune system
•Temperature
•blood pressure homeostasis
- sealing damaged blood vessels with blood clots
what are the two components of whole blood?
plasma (fluid portion) & formed elements (cellular portion)
what is plasma made of?
90% water
9% plasma proteins
1% dissolved solutes
most plasma proteins are produced by...
liver
what plasma proteins does the liver produce?
- albumin (maintains blood volume via drawing water into the blood through osmosis)
- transport proteins (bind & transport lipid based substances in the blood)
- clotting proteins (participate in clotting cascade to form a blood clot)
what are gamma globulins?
aka antibodies located in the plasma that are proteins made by cells of the immune system called B lymphocytes
what are the 3 classes of formed elements?
erythrocytes (44% of blood volume)
platelets (1%)
leukocytes (less than 1%)
what are erythrocytes?
most numerous blood cells that are reddish pink colored and lack a nucleus & most organelles
what is hematocrit?
the ratio of the volume of red blood cells to the total volume of blood (ex: in males the RBC count is 40-50% of total blood volume)
what are platelets?
cellular fragments involved in clotting that lack nuclei & most organelles & are very small
what are leukocytes?
white blood cells that play a role in the immune system
how are leukocytes classified?
Based on the presence or absence of visible cytoplasmic granules.
how are the 3 types of granulocytes named?
based on the type of stain they best interact with when treated with the dyes hematoxylin & eosin (neutrophils, basophils, & eosinophils)
what are neutrophils?
granulocyte that doesn't react strongly with hematoxylin or eosin dyes
- stains light violet pink
- most numerous WBC
- multi lobed nuclei
- aka polymorphonucleocytes because their nuclei can vary in shape

what are eosinophils?
granulocyte that stains bright red
- participates in allergic reactions
- responds to parasitic infections

what are basophils?
granulocyte that stains dark blue-purple due to hematoxylin
- least numerous WBC
- primarily involved in allergic response
